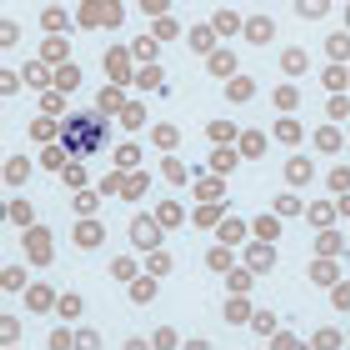

An ever-deeper understanding of the biology that drives NSCLC is sparking new treatment paradigms that include selecting targeted drugs based on patients' biomarkers.

Your AI-Trained Oncology Knowledge Connection!


An ever-deeper understanding of the biology that drives NSCLC is sparking new treatment paradigms that include selecting targeted drugs based on patients' biomarkers.

Despite missing its main goals, the PointBreak trial did provide guidance about how best to structure maintenance therapy in NSCLC, and it proved that an option besides paclitaxel is available.

Mark G. Kris, MD, offers insight into NSCLC related topics, including emerging therapeutic targets, the optimal application of TKIs, strategies for patients with poor performance status, maintenance therapies, and the treatment pipeline.

After wrangling between Democrats and Republicans pushed a decision beyond a year-end deadline, the federal government passed the American Taxpayer Relief Act of 2012 and averted the "fiscal cliff."

For the past six years, researchers have been working to develop a treatment for patients with CML who have become resistant to the groundbreaking drug imatinib and to the TKIs dasatinib and nilotinib that were developed subsequently.

An interview with Jenny C. Chang, MB BChir, MD, who broke new ground in cancer research when she identified and patented a 493-gene signature for breast cancer.

Proposed federal budget cuts that could affect the National Institutes of Health, and thus hematology/oncology research, were highlighted as an area of concern during the 54th Annual Meeting of the American Society of Hematology in Atlanta, Georgia.

Researchers have demonstrated that ponatinib can overcome a wide range of mutations that cause treatment resistance-including the stubborn T315I mutation-in all stages of CML and Ph+ ALL.

MLN9708 has shown comparable efficacy and greater convenience and tolerability than bortezomib, for patients with multiple myeloma.

An interview with Nicholas J. Vogelzang, MD, a researcher who has changed the course of cancer treatment by helping to develop therapies for prostate cancer, kidney cancer, bladder cancer, testicular cancer, and mesothelioma.

For those who treat overweight or obese cancer patients, choosing doses of chemotherapy can be a sweat-producing endeavor.

Many researchers and oncologists anticipate a role for antiangiogenic strategies in future treatment paradigms; yet just what that role will be remains elusive.

The promise of a solution somewhere on the horizon for America's drug shortages isn't enough for the registered nurse who navigates shortages every day.

Within the past two years, the oncology community has seen the FDA approve three practice-changing therapies for breast cancer and the progress of a promising fourth agent, T-DM1.

During the 11th International Congress on The Future of Breast Cancer, Hope Rugo, MD, offered a snapshot of the research community's progress in the study and treatment of the disease.
Anemia is common and associated with functional disability in patients with cancer aged ≥65 years, according to the results of a study presented at ASCO 2012.

Patients with cancer who have lower incomes are less likely to participate in clinical trials, according to a large national survey.

Fresh strategies for grappling with the chronic, and at times critical, shortages of cancer drugs that have frustrated the oncology community for the past decade are likely to help alleviate supply problems.

Two medications that are not recommended in guidelines for the standard treatment of cancer-related febrile neutropenia are commonly used- particularly outside of high-volume medical settings- yet are not effective.

The novel drug enzalutamide (formerly MDV3100) significantly improved overall survival in men with metastatic castrate-resistant prostate cancer (mCRPC).

Among patients with early-stage cervical cancer, women aged greater than 65 years are less likely than younger women to be treated with surgery as compared with chemoradiation.

Men with a baseline PSA between 1.5 and 4.0 ng/mL faced a 15-fold increase in prostate cancer over a four-year period as compared with men whose baseline PSA levels were

Since the phase III AFFIRM trial of enzalutamide was halted after meeting its endpoint of improved OS, physicians have remained hopeful about its potential as a treatment for prostate cancer.

Leaders in the oncology care and research communities largely applauded the US Supreme Court ruling Thursday that upholds the Affordable Care Act.

Enzalutamide seems poised to become an exciting addition to the growing list of novel therapies approved for the treatment of prostate cancer.

An interview with David Cella, PhD, the developer of the FACIT system of questionnaires that scientifically measure the quality of life of patients being treated for cancer.

Checking in with patients can bring positive results, since oncology nurses are able to offer interventions for most symptoms of cancer treatment. Includes an in-depth look at telephone triage.

Three case studies focused on how best to sequence therapy in prostate cancer were presented by Daniel P. Petrylak, MD, and discussed by a panel that included Robert Dreicer, MD, and Oliver Sartor, MD.

Only half of those with breast cancer and one-quarter of those with colon cancer were referred for genetic counseling or testing by their physicians.

Drug manufacturers are working with the FDA to report anticipated shortages earlier and ensure alternative sources of needed drugs are available.